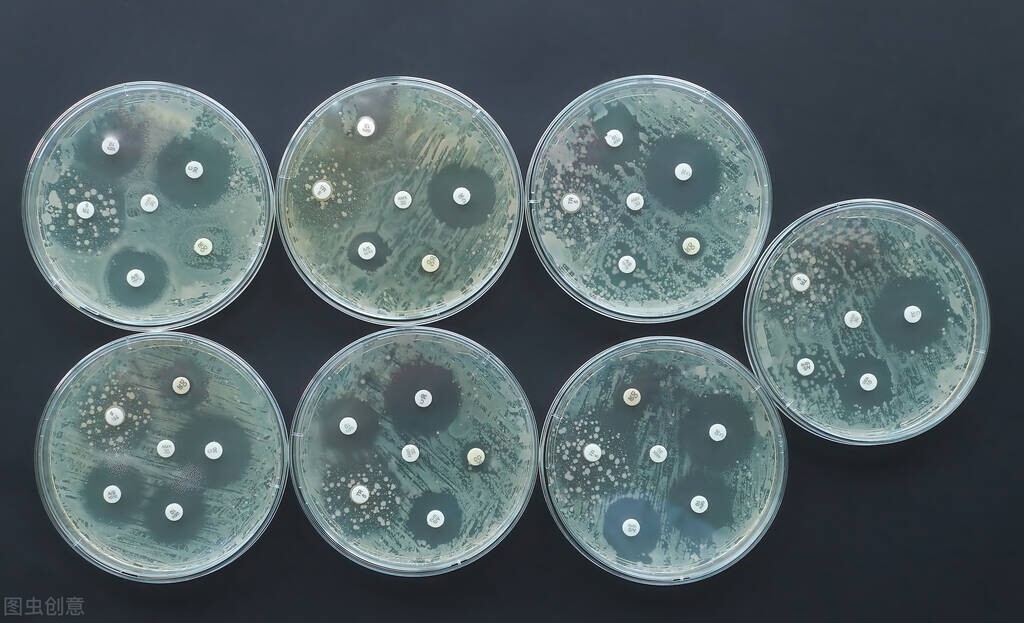
尿常规正常，没有尿痛，淋球菌检查却阳性！为何他的淋病反复不愈
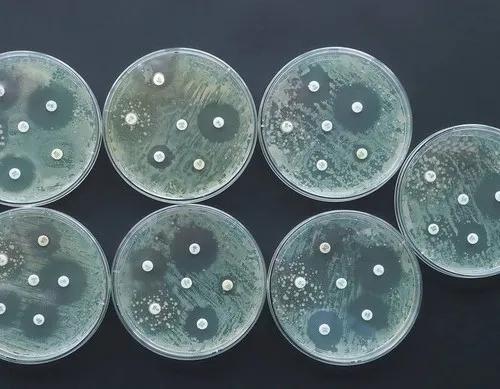
尿常规正常，没有尿痛，淋球菌检查却阳性！为何他的淋病反复不愈

下午,医院院感科打电话通知我,我的一位患者检查淋球菌阳性,让我别忘了上报传染病报告卡。

这位病人我印象深刻,他两个月前尿道疼痛流脓,在外院检查出淋病,使用了药物后,自感症状消失。不想四天前尿道口又出现少量粘液样分泌物,虽没有明显尿频尿痛,但考虑到之前曾经有淋球菌感染,就有点放心不下,到医院让我给他再查查。
虽然患者极力否认有乱搞两性关系的风流史,只承认发病前跟自己正式的女友有过*生活性**。但我仍高度怀疑他淋病复发了。

当时给他做了个尿常规,还做了支原体、衣原体、淋球菌检查。
很快尿常规结果出来了,竟然是正常的!这让我对自己的判断产生了一丝怀疑,难道他并没有淋球菌复发?
考虑到淋球菌感染本来就有一部分人不会有任何症状,其中,男性约10%,女性约50%为无症状感染者,尿常规也可以是正常的。所以他的尿常规正常并不能完全排除淋球菌感染!
现在,淋球菌检查结果出来了,他果真淋球菌复发了(也可能是之前并没有完全治愈)!
这位患者淋病反复不愈的原因何在呢?

国内外也有些淋病反复不愈的病人,多是不规范使用抗生素,使淋球菌对药物产生了耐药性所致。既往治疗淋病的经典药物如青霉素和四环素,基本对淋球菌不再有作用。
据朱有葱等“益阳地区淋病流行特征及耐药淋球菌菌株分型的调查研究”,益阳地区淋球菌对环丙沙星的耐药性达到94.5%;青霉素的耐药性88.0%;四环素的耐药性77.5%;阿奇霉素的耐药性12.5%,头孢曲松及壮观霉素的耐药性均为0。
王辉等“上海市某教学医院淋病奈瑟菌耐药特征及耐药机制”,报道了同济大学附属东方医院南院淋球菌的耐药特征 ,发现淋球菌对青霉素、头孢曲松、头孢克肟、四环素、环丙沙星、大观霉素和阿奇霉素的耐药性分别为100%、1.4%、17.6%、99.3%、99.3%、0%和8.5%。
国内外的学者们观察到,淋球菌对药物的抵抗力正随着药物的不规范使用在逐渐增加!
因此,国内外指南都推荐规范使用治疗淋球菌的药物,防止其耐药性增加!
其中,美国的指南建议使用头孢曲松治疗淋病(老版指南建议联用阿奇霉素,由于淋球菌对阿奇霉素耐药性增加,新版指南已经去除了阿奇霉素)。我国则建议使用头孢曲松或者大观霉素作为一线治疗淋病的方案。
即使是治疗淋病的王牌药物头孢曲松,近年来耐药的比例也在增加。
因此,国内外对头孢曲松的使用剂量也适当进行了增加调整。比如针对没有并发症的单纯性淋病,我国2014年版指南、美国2015年版指南推荐都使用250mg头孢曲松单剂量应用。而最新版的美国指南(2020年版),推荐使用500mg头孢曲松,我国指南(2020年版)则推荐使用1g头孢曲松!
看来,小剂量治不住它了!
国内一些小诊所对淋病的治疗并不规范,使用一些并非一线的药物,效果可能并不理想,虽然病人的症状有可能消失,但并不代表淋病已经治愈!因为即使未经治疗的淋病,一般患者在10~14天后症状也会逐渐减轻,1个月后症状基本消失,但此时疾病并未痊愈,淋球菌可继续向后尿道或上生殖道扩散,甚至发生并发症。
不规范的治疗,这正是淋病患者病情反复的一个重要原因。
还有一个因素导致病人淋病反复:得了淋病的患者,往往不愿让别人,特别是自己最亲密的伴侣,知道自己的病情!而淋病作为一种性病,非常可能已经传染给了伴侣(她可能没有症状)!不告诉伴侣,伴侣无法同查同治,那么,即使一方治好了淋病,双方性接触后,淋球菌又可以再次感染过来!#行家计划##了不起的中国医师##家庭健康守护官#